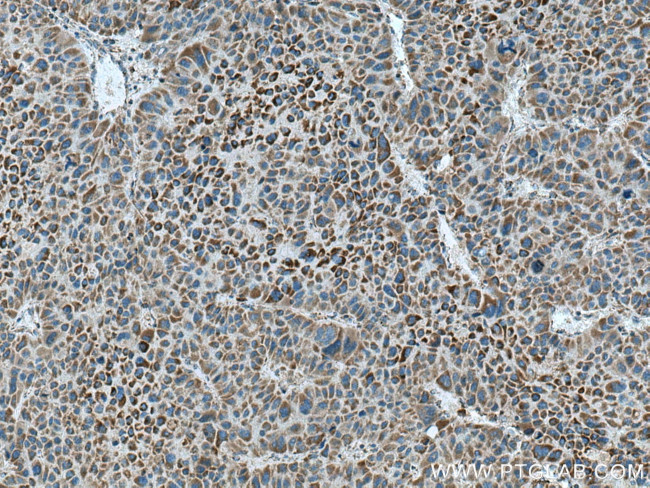
CPOX Antibody in Immunohistochemistry (Paraffin) (IHC (P))

Search
Proteintech
CPOX Polyclonal Antibody
{{$productOrderCtrl.translations['antibody.pdp.commerceCard.promotion.promotions']}}
{{$productOrderCtrl.translations['antibody.pdp.commerceCard.promotion.viewpromo']}}
{{$productOrderCtrl.translations['antibody.pdp.commerceCard.promotion.promocode']}}: {{promo.promoCode}} {{promo.promoTitle}} {{promo.promoDescription}}. {{$productOrderCtrl.translations['antibody.pdp.commerceCard.promotion.learnmore']}}
产品信息
12211-1-AP
种属反应
已发表种属
宿主/亚型
分类
类型
抗原
偶联物
形式
浓度
规格
纯化类型
保存液
内含物
保存条件
运输条件
产品详细信息
Immunogen sequence: MALQLGRLS SGPCWLVARG GCGGPRAWSQ CGGGGLRAWS QRSAAGRVCR PPGPAGTEQS RGLGHGSTSR GGPWVGTGLA AALAGLVGLA TAAFGHVQRA EMLPKTSGTR ATSLGRPEEE EDELAHRCSS FMAPPVTDLG ELRRRPGDMK TKMELLILET QAQVCQALAQ VDGGANFSVD RWERKEGGGG ISCVLQDGCV FEKAGVSISV VHGNLSEEAA KQMRSRGKVL KTKDGKLPFC AMGVSSVIHP KNPHAPTIHF NYRYFEVEEA DGNKQWWFGG GCDLTPTYLN QEDAVHFHRT LKEA (1-303 aa encoded by BC023551)
靶标信息
The protein encoded by this gene is the sixth enzyme of the heme biosynthetic pathway. The encoded enzyme is soluble and found in the intermembrane space of mitochondria. This enzyme catalyzes the stepwise oxidative decarboxylation of coproporphyrinogen III to protoporphyrinogen IX, a precursor of heme. Defects in this gene are a cause of hereditary coproporphyria (HCP).
仅用于科研。不用于诊断过程。未经明确授权不得转售。
生物信息学
蛋白别名: clone 560; coprogen oxidase; Coproporphyrinogen III oxidase, mitochondrial precursor (Coproporphyrinogenase) (Coprogen oxidase) (COX); coproporphyrinogen-III oxidase, mitochondrial; coproporphyrinogenase; COX; cpox {ECO:0000312|EMBL:AAI07665.1}; homozygous coproporphyria; Oxygen-dependent coproporphyrinogen-III oxidase, mitochondrial; unnamed protein product
基因别名: cac; COX; CPO; CPOX; CPX; HARPO; HCP; nct
UniProt ID: (Human) P36551, (Rat) Q3B7D0, (Mouse) P36552
Entrez Gene ID: (Human) 1371, (Rat) 304024, (Mouse) 12892